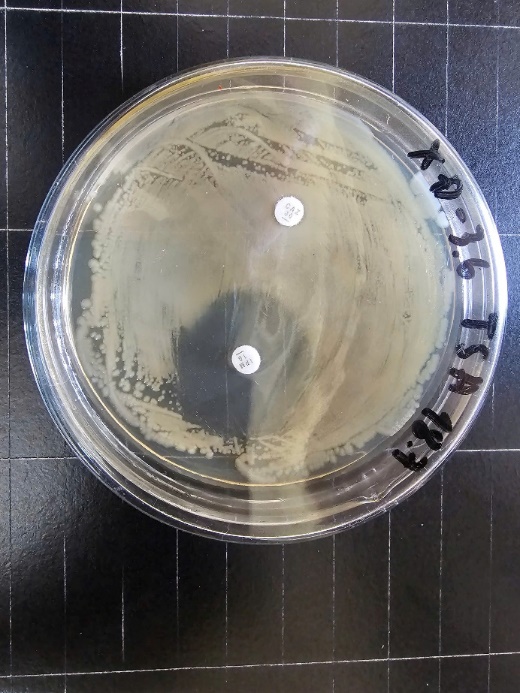

Trong năm 2025, Phòng Sinh thái và Môi trường biển đã chủ trì 7 đề tài các cấp và 5 hợp đồng với địa phương:
- Đề tài các cấp: 01 nhiệm vụ hợp tác quốc tế cấp quốc gia, 02 đề tài trọng điểm cấp Viện Hàn lâm, 01 nhiệm vụ hợp tác quốc tế cấp Viện Hàn lâm, 02 đề tài cấp tỉnh và 01 đề tài Cơ sở chọn lọc.
- Các Hợp đồng dịch vụ bao gồm Công ty Australis tại Khánh Hòa, Nhà máy Nhiệt điện BOT Vân Phong 1, Viện Nghiên cứu Nuôi trồng Thủy sản III, Ban quản lý vườn quốc gia Côn Đảo và Chi cục Khoáng sản và Bảo vệ môi trường.
Về công bố khoa học: Các cán bộ trong phòng đã công bố 24 công trình trên các Tạp chí chuyên ngành quốc gia và quốc tế uy tín; trong đó, có 7 công trình thuộc danh mục SCIE/Scopus (4 công trình thuộc Q1, số còn lại là SCIE/Scopus Q2 và Q4), 6 công trình thuộc danh mục Tạp chí Quốc gia, 2 cuốn sách chuyên khảo, 1 chương sách chuyên khảo và 7 công trình trong các Kỷ yếu hội thảo quốc tế và quốc gia.
Viên chức/cán bộ nghiên cứu Phòng Sinh thái và Môi trường biển và các phòng/trung tâm khác tham gia Đoàn khảo sát trên tàu Viện sĩ OPARIN (02/5/2025– 26/5/2025)
I. NHIỆM VỤ KHOA HỌC CÔNG NGHỆ CÁC CẤP ĐANG THỰC HIỆN
- Nhiệm vụ hợp tác quốc tế về khoa học và công nghệ theo nghị định thư với Italy, nhiệm vụ cấp quốc gia: “Nghiên cứu các giải pháp giám sát biến động phục vụ bảo tồn đa dạng sinh vật đáy vùng ven biển Nam Trung Bộ Việt Nam dưới tác động của quá trình đô thị hóa”, NĐT/ITA/24/09, chủ nhiệm: TS Nguyễn Hữu Huân.
- Hợp phần số 1 thuộc Đề án trọng điểm cấp Viện Hàn lâm KHCNVN: “Xây dựng bộ số liệu về một số độc chất môi trường tại vùng biển ven bờ Phú Yên, Khánh Hoà và Ninh Thuận”, TĐĐTMT.01/24-26, chủ nhiệm: TS. Hoàng Xuân Bền.
- Hợp phần số 4 thuộc Đề án trọng điểm cấp Viện Hàn lâm KHCNVN: “Xây dựng hồ sơ một số chủng vi khuẩn có hại trong cá Chim, tôm Hùm, Hàu nuôi tại vùng biển Phú Yên và Khánh Hòa”, TĐĐTMT.04/24-26, chủ nhiệm: TS. Phạm Thị Miền.
- Nhiệm vụ hợp tác quốc tế cấp Viện Hàn lâm: “Tổ chức khảo sát thu thập mẫu đa dạng sinh học và hóa sinh trong vùng biển Việt Nam bằng tàu Viện sĩ Oparin”, QTRU02.02/25-26, chủ nhiệm: TS. Hoàng Xuân Bền.
- Đề tài tỉnh Bà Rịa – Vũng Tàu: “Nghiên cứu sinh sản nhân tạo ốc Đụn Cái (Rochia nilotica) ở Vườn quốc gia Côn Đảo”, chủ nhiệm: TS. Hoàng Xuân Bền.
- Đề tài tỉnh Bà Rịa – Vũng Tàu: “Nghiên cứu sức chịu tải môi trường phục vụ lập kế hoạch phát triển vùng nuôi trồng thủy sản bền vững tỉnh Bà Rịa – Vũng Tàu”, chủ nhiệm: ThS. Phan Minh Thụ (Nghiệm thu và thanh lý hợp đồng ngày 3/3/2025).
- Đề tài Cơ sở chọn lọc: “Nghiên cứu quá trình giải phóng phospho từ trầm tích ở vịnh Cam Ranh, Khánh Hòa”, CSCL17.01/24-25, chủ nhiệm: ThS Lê Hùng Phú.
Hoạt động trao đổi khoa học với Trường Đại học Bologna (Italy) thuộc Nhiệm vụ hợp tác quốc tế về khoa học và công nghệ theo nghị định thư với Italy, NĐT/ITA/24/09
Hoạt động khảo sát của Hợp phần số 1 thuộc Đề án trọng điểm cấp Viện Hàn lâm KHCNVN (TĐĐTMT.01/24-26).
Các Hợp đồng dịch vụ
- Hợp đồng với Ban quản lý vườn quốc gia Côn Đảo “Xây dựng quy trình sản xuất giống nhân tạo và các mô hình nuôi nhằm phục hồi, phát triển tái tạo quần đàn ốc Đụn Cái Rochia nilotica ở Vườn quốc gia Côn Đảo” (chủ trì: TS. Hoàng Xuân Bền);
- Hợp đồng với Chi cục Khoáng sản và Bảo vệ môi trường (trước đây là Chi cục Bảo vệ môi trường tỉnh Ninh Thuận) “Nghiên cứu xây dựng dự thảo Kế hoạch hành động về bảo tồn đa dạng sinh học tỉnh Ninh Thuận đến năm 2030 và tầm nhìn đến năm 2050 theo tinh thần của “Quy hoạch tỉnh Ninh Thuận thời kỳ 2021 – 2030, tầm nhìn đến năm 2050”, góp phần thực hiện Quyết định số 149/QĐ-TTg ngày 28/1/2022 của Chính phủ phê duyệt “Chiến lược quốc gia về ĐDSH đến năm 2030, tầm nhìn đến năm 2050” (chủ trì: TS. Hoàng Xuân Bền);
- Hợp đồng Giám sát hệ sinh thái biển tại Nhà máy Nhiệt điện BOT Vân Phong 1 (chủ trì: TS. Hoàng Xuân Bền);
- Hợp đồng với Công ty TNHH thủy sản Australis Việt Nam: Quan trắc môi trường vùng nuôi biển của công ty Australis ở vịnh Vân Phong (chủ trì: TS. Nguyễn Hữu Huân);
- Hợp đồng với Viện Nghiên cứu Nuôi trồng Thủy sản III: Phân tích các chỉ tiêu kim loại (Cd, Cu, Hg, Pb) trong mẫu bùn, trong nuôi tôm thâm canh khu vực duyên hải miền Trung (chủ trì: ThS. Phạm Hồng Ngọc).
Một số kết quả của Hợp phần số 4 thuộc Đề án trọng điểm cấp Viện Hàn lâm KHCNVN (TĐĐTMT.04/24-26)
II. MỘT SỐ CÔNG BỐ KHOA HỌC TIÊU BIỂU
Tạp chí thuộc danh mục SCIE/Scopus
- Minh-Thu, P.*, The, H. V.*, Ben, H. X., Hieu, N. M., Phu, L. H., Dung, L. T., Ngoc, P. H., Linh, V. T. T., Mien, P. T., Ha, T. T., Thang, N. T. X., Vinh, H. T., & Viet Ha, D. (2025). Eutrophication Monitoring for Sustainable Development in Nha Trang Marine Protected Area, Vietnam. Sustainability, 17(11), 5128. DOI: 10.3390/su17115128.
- Ben, H. X., Thinh, T. C., Minh-Thu, P.* (2025). A Dataset of Environmental Toxins for Water Monitoring in Coastal Waters of Southern Centre, Vietnam: Case of Nha Trang Bay. Data 10, 155. DOI: 10.3390/data10100155.
- Ho Son Lam, Nguyen-Thi Nguyet Hue, Dang-Tran Tu Tram, Do-Hai Dang, Hoang-Xuan Ben, Dao-Viet Ha, Do-Huu Hoang (2025). Interactive effects of Lugol concentrations and soaking durations on physiology of fragment of soft coral, Sarcophyton serenei (Tixier-Durivault, 1958). Regional Studies in Marine Science, 83, 104078, 1-7, 2025. DOI: 10.1016/j.rsma.2025.104078.
- Hoang Son Tran, Dinh Quang Vu, Dang Quang Nguyen, Duc Thinh Bui, Thu Uyen Do, Thi Thu Hang Le, Thi Thanh Tam Tran, Hoang Nam Pham, Kim Hanh Nguyen, Trung Du Hoang, Anne-Laure Banuls, Gwenn Pulliate, Sylvain Thery, Yvan Bettarel, Jean-Christophe Auguet, Quang Huy Nguyen (2025). Occurrence of multidrug-resistant Enterobacteriaceae and antibiotic-resistant genes in the anthropogenic impacted bay of Nha Trang, Viet Nam. Regional Studies in Marine Science 83, 104084. DOI: 10.1016/j.rsma.2025.104084.
- Nguyen, X.-V.; Hoang, T.-D.; Nguyen-Nhat, N.-T.; Nguyen, Q.-H.; Nguyen, X.-T.; Nguyen, T.-H.; Truong, S.H.T.; Nguyen, M.-N.T.; Dao, V.-H. (2025). Polycyclic Aromatic Hydrocarbons (PAHs) and Phthalate Esters (PAEs) in the Farmed Fishes from Khanh Hoa, Viet Nam: Level and Health Risk Assessment. Foods 14, 3518. DOI: 10.3390/foods14203518.
- Long Van Nguyen, Quang Minh Thai, Dat Xuan Mai, My Thao Nguyen‑Le, Hong Kim Thi Phan, Ben Xuan Hoang, Ha Viet Dao, Marina Malyutina (2025). Spatial recruitment patterns of Chaetodon butterflyfishes on coral reefs in the coastal waters of Vietnam. Environ Biol Fish (2025) 108:211–226. DOI: 10.1007/s10641-024-01658-4.
- Lam H. S., Hue N. T. N., Ngoc D. T. H., Tram D. T. T., Dang D. H., Tai N. T. T., Ben H. X., Ha D. V., Khanh P. T., Ngan N. T. M., Minh-Thu P.* (2025). Improvement of reproductive performance of clown anemonefish, Amphirion ocellaris (Cuvier, 1830), with vitamin C. AACL Bioflux 18(1):185-199. (e-ISSN 1844-9166, Scopus).
Sách chuyên khảo
- Hoàng Xuân Bền (2025). San hô tám ngăn (Octocorallia haeckel, 1866) vùng biển phía nam Việt Nam. Sách chuyên khảo, Nhà xuất bản Khoa học tự nhiên và Công nghệ, Viện Hàn lâm Khoa học và Công nghệ Việt Nam.
- Cao Văn Nguyện, Huỳnh Minh Sang, Phan Minh Thụ (2024). Nguồn lợi Hàu biển Việt Nam: Sinh thái và Kỹ thuật nuôi nâng cao. Bộ sách Chuyên khảo về Biển và Công nghệ biển. NXB. Khoa học Tự nhiên và Công nghệ.
III. THAM GIA CÁC HỘI THẢO/TRAO ĐỔI KHOA HỌC
- Đoàn ra: Phòng đã có 2 đoàn ra trao đổi khoa học, tập huấn tại Nhật Bản và Hàn Quốc
- Đoàn vào: Phòng đã tiếp đoàn Đại học Bremen (Đức), Trường Đại học Bologna (Italy).
IV. CÔNG TÁC ĐAO TẠO
- Hoàng Xuân Bền đang hướng dẫn 1 nghiên cứu sinh của Học viện Khoa học và Công nghệ (GUST), 02 học viên cao học của GUST, Đại học Nha Trang và 2 sinh viên ĐH Giao thông vận tải TP. Hồ Chí Minh
- Phạm Thị Miền đang hướng dẫn 01 học viên cao học của Trường ĐH Công thương TP. Hồ Chí Minh.
V. CÔNG TÁC KHÁC
- Hoàng Xuân Bền và TS. Nguyễn Hữu Huân hoàn thành nhiệm vụ biên tập viên cho các tạp chí Quốc gia, tạp chí VAST